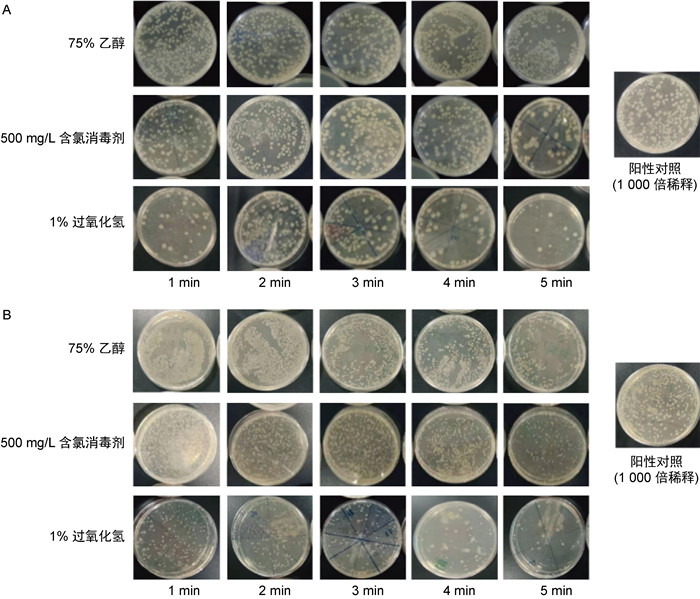
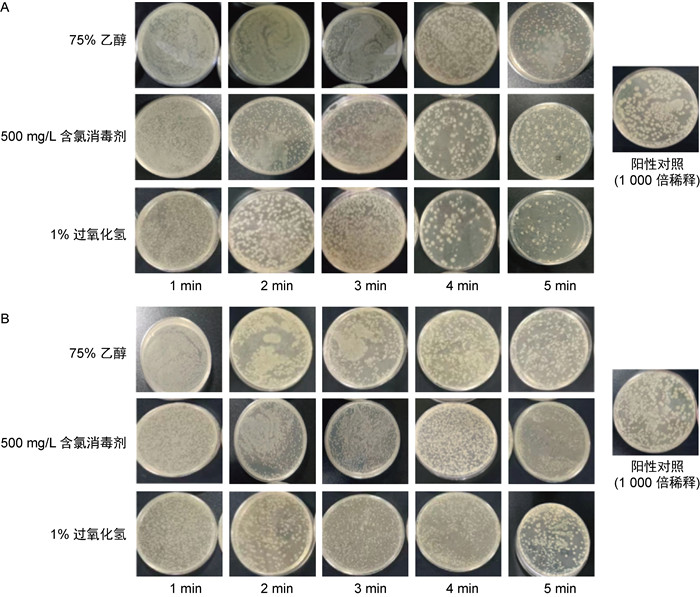
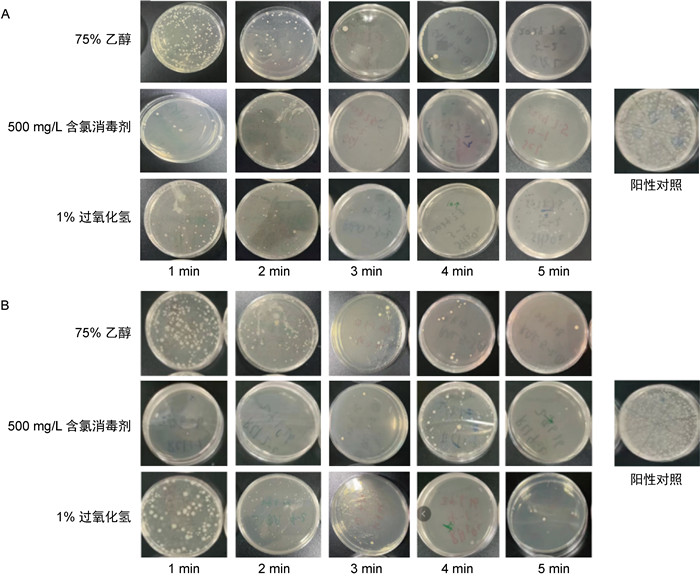

2. 复旦大学三级生物安全实验室,上海 200032
2. Biosafety Level 3 Laboratory, Fudan University, Shanghai 200032
消毒在公共卫生工作中扮演着不可或缺的重要角色,是控制和预防传染病传播的核心措施之一。有效的消毒处理可以迅速、彻底地消灭环境中的病原微生物,包括细菌、病毒和真菌,从而大幅降低疾病发生和传播的风险。作为突发公共卫生事件,SARS-Cov-2大流行也进一步印证了构建完善的生物安全措施和条例、打造成熟的消毒卫生屏障对于防止感染扩散的重要性[1]。环境中部分微生物可以存活数月之久,可持续将污染扩散至接触的人群、个体或其他接触物。因此,被污染表面可看作病原体储集层和第二转移宿主之间的中转站。针对其表面结构类型、携带的微生物类型和消毒剂的使用方法制定特定的消毒方案,对于获得最佳消毒效果至关重要[2]。
使用消毒剂的主要目的是为了降低病原体感染人体和感染性疾病传播的风险。为了达到这个目标,专业技术人员须对消毒剂类型及其使用方法进行总结。此外,由于病原菌的种类和耐药性不同,及时修订和评估各种化学消毒剂的功效也至关重要。然而,由于不同品牌的消毒产品的可及性不同,如何选择正确的消毒剂和消杀方式已成为卫生保健机构、环境卫生专家和感染控制监督人员所面临的挑战之一[3]。另一方面,为了预防病原体的传播,消毒程序须具备在高风险区域(如实验室、手术室、重症监护病房或食品加工场所)进行大面积、高效、快速消杀的能力。因此,当下消毒剂的消毒效应评估应当包括如下4个方面:具有广谱抗微生物特性、消杀起效迅速、与多种消杀场景兼容、对人类和环境安全[4]。
基于以上考量,本研究检测并比较了目前常用的几种消毒剂在实验室和现场两种场景下对光滑表面及有孔有缝表面的快速消毒效果,为后续选用有效的消毒剂提供依据。
1 材料与方法 1.1 材料 1.1.1 消毒剂75%乙醇购于国药集团化学试剂有限公司,1%过氧化氢购于上海巴司德尼生物科技有限公司,500 mg/L含氯消毒剂购于上海巴司德尼生物科技有限公司。
1.1.2 菌株大肠埃希氏菌8099和金黄色葡萄球菌(ATCC 6538)均由上海市疾病预防控制中心惠赠。
1.1.3 试剂胰蛋白胨大豆琼脂(tryptose soya agar,TSA)培养基购自北纳生物,磷酸缓冲盐溶液(phosphate buffered saline,PBS)(0.03 mol/L,pH 7.2)、0.1%硫代硫酸钠和0.1%吐温80的生理盐水根据消毒剂的检测报告自行配制。
1.1.4 实验场景使用不锈钢材质表面模拟平整光滑表面,采用织物表面模拟有孔有缝隙表面。
1.2 方法 1.2.1 制备细菌繁殖体悬液分别挑取平板上的单克隆菌落[大肠埃希菌8099和金黄色葡萄球菌(ATCC 6538)],置于36 ℃(±1 ℃)下培养24 h。用接种环取第1代培养的菌悬液,划线接种于营养琼脂培养基平板上,置于37 ℃培养24 h,挑取上述第2代培养物中的典型菌落,接种于营养琼脂斜面,置于37 ℃培养24 h,即为第3代培养物。取第3代的营养琼脂培养基培养24 h的新鲜斜面培养物[5],吸取3.0 mL PBS加入试管内,反复吹吸洗下菌苔。随后,将液体转移至另一无菌试管中,使菌体均匀悬浮。将菌悬液浓度稀释至5×108 CFU/mL备用。
1.2.2 实验室消毒效果检测将平整光滑和有孔有缝隙物品表面清洁后,用大肠埃希菌8099和金黄色葡萄球菌(ATCC 6538)分别对2种表面进行人工染菌。使用一次性采样棉签,取500 mL菌液(浓度约为108 CFU/mL)均匀涂抹在采样框(5 cm× 5 cm)内。每次每组实验均设阳性对照组和实验组。实验组染菌后待表面自然干燥后进行消毒。消毒前取3块染菌的区块作为阳性对照组。实验组消毒剂(75%乙醇、1%过氧化氢、500 mg/L含氯消毒剂) 使用统一喷壶分别装配,在距离采样框正上方20 cm处喷洒2泵,使消毒剂可均匀浸泡5 cm×5 cm采样框。分别于消毒后5个时间点采样(1 min~5 min每分钟取样1次),每个时间点采5个样本,每个采样框相邻20 cm。
采样方法:将一次性棉签置于采样框内涂抹采样,分别横向来回涂抹8次,纵向来回涂抹8次,重复2次。采样结束后将棉签放入含10 mL中和剂的15 mL离心管内。取1 mL样本,每个样本分别进行10、100、1 000和10 000倍梯度稀释后,以倾注法各接种1个营养琼脂培养基平皿。将平皿置于36 ℃±1 ℃恒温培养箱中培养48 h,观察记录最终结果并计算每次实验的每个样本的平均杀灭对数值。每次实验未用完的同批次稀释液、采样棉签、培养基等设为阴性对照,实验重复3次。按照KL=No-Nx(KL:杀灭对数值;No:对照组平均活菌浓度的对数值;Nx:实验组活菌浓度对数值)计算杀灭对数值。活菌浓度:取1 mL当天染菌用菌液加至9 mL中和剂内,分别稀释105、106、107倍,各取1 mL以倾注法接种平皿,置于37 ℃恒温培养箱中培养24 h后计数,计算每毫升的活菌数[5]。
1.2.3 现场消毒效果检测在现场每日预防性消毒前开展实验。用规格板对现场的物体表面(光滑表面、有孔有缝隙物品)分别标定面积为25 cm2的区块。于消毒前及实验组(分别使用75%乙醇、1%过氧化氢、500 mg/L含氯消毒剂)消毒后5个时间点采样(1 min~5 min每分钟取样1次),并进行中和、稀释,每个时间点采集5个区块[5]。采样后的样本分别取1 mL以倾注法接种平皿,置于37 ℃恒温培养箱中培养48 h,观察并记录最终结果。消毒前取3个区块作为阳性对照,计算每次实验的平均杀灭率。将每次实验未用完的同批次中和剂、稀释液、采样棉签、培养基等设为阴性对照,实验重复3次。用公式[(消毒后平均样本菌数/消毒前平均样本菌数)×100%]计算每种消毒剂对消毒对象表面自然菌的平均杀灭率[5]。
2 结果 2.1 实验室消毒效果比较 2.1.1 3种消毒剂对实验室中光滑表面的快速消毒效果如图 1、图 2所示,在光滑表面,3种消毒剂对大肠埃希菌8099和金黄色葡萄球菌(ATCC 6538)在消毒1 min后,均有一定的消毒效果,但75%乙醇、1%过氧化氢、500 mg/L含氯消毒剂的消毒效果略有不同。
|
| A:大肠埃希菌8099;B:金黄色葡萄球菌(ATCC 6538)。 图 1 3种消毒剂对实验室光滑表面的消毒效果 Fig. 1 Disinfection effect of three disinfectants on smooth surfaces in the laboratory |

|
| A:大肠埃希菌8099;B:金黄色葡萄球菌(ATCC 6538)。 图 2 3种消毒剂对实验室光滑表面消毒效果评价 Fig. 2 Evaluation of the disinfection efficacy of three disinfectants on smooth surfaces in the laboratory |
1%过氧化氢消毒剂对大肠埃希菌8099的消毒效果明显好于75%乙醇及500 mg/L含氯消毒剂,前者在5个时间点的杀灭对数值均大于5。500 mg/L含氯消毒剂的消毒效果略优于75%乙醇,前者的杀灭对数值均大于3,而75%乙醇的杀灭对数为2~3。(见图 1A、2A)
1%过氧化氢对金黄色葡萄球菌(ATCC 6538)的消毒效果好于75%乙醇及500 mg/L含氯消毒剂,前者在消毒后1 min时的杀灭对数值为4.56,其余时间点均大于5。500 mg/L含氯消毒剂的消毒效果在消毒后1 min~4 min内略优于75%乙醇,而两者的消毒效果在消毒后5 min时相似。500 mg/L含氯消毒剂及75%乙醇在各时间点对金黄色葡萄球菌(ATCC 6538)的杀灭对数值均大于3(见图 1B、2B)
2.1.2 3种消毒剂对实验室中有孔有缝表面的快速消毒效果如图 3、图 4所示,在有孔有缝表面,75%乙醇、1%过氧化氢、500 mg/L含氯消毒剂3种消毒剂在消毒1 min后对大肠埃希菌8099和金黄色葡萄球菌(ATCC 6538)均有一定的消毒效果,但效果略有不同。对于大肠埃希菌8099,消毒后2 min内1%过氧化氢的消毒效果好于75%乙醇及500 mg/L含氯消毒剂,3 min后1%过氧化氢的消毒效果有所下降,但其杀灭对数值均大于3。500 mg/L含氯消毒剂的消毒效果略优于75%乙醇,在消毒后5 min内其杀灭对数值为3~4,而75%乙醇的杀灭对数值为2~3(详见图 3A、图 4A)。对于金黄色葡萄球菌(ATCC 6538),500 mg/L含氯消毒剂的消毒效果略好于1%过氧化氢及75%乙醇,其在消毒后2 min内的杀灭对数值与75%乙醇类似,但3 min后的杀灭对数值高于1%过氧化氢及75%乙醇。1%过氧化氢的消毒效果在1 min~4 min时为三者中最低。至消毒后5 min,3种消毒剂的杀灭对数值相似。3种消毒剂在5个时间点的杀灭对数值均为3~5(详见图 3B、图 4B)。
|
| A:大肠埃希菌8099;B:金黄色葡萄球菌(ATCC 6538)。 图 3 3种消毒剂对实验室有孔有缝表面的消毒效果 Fig. 3 Disinfection effect of three disinfectants on porous and cracked surfaces in the laboratory |

|
| A:大肠埃希菌8099;B. 金黄色葡萄球菌(ATCC 6538)。 图 4 3种消毒剂对实验室有孔有缝表面的消毒效果评价 Fig. 4 Evaluation of the disinfection efficacy of three disinfectants on porous and cracked surfaces in the laboratory |
在现场消毒时,1%过氧化氢、500 mg/L含氯消毒剂对光滑表面的消毒效果类似,且能够达到一定的消毒效果。1%过氧化氢在消毒后1 min时的平均杀灭率接近80%,2 min~5 min的平均杀灭率均大于90%。500 mg/L含氯消毒剂在5个时间点的平均杀灭率均大于90%。75%乙醇的平均杀灭率低于其余2种消毒剂,在消毒后1 min时仅为51.52%,之后有所提升,但平均杀灭率均低于90%(见图 5A、图 6A)。
|
| A:光滑表面;B:有孔有缝表面。 图 5 3种消毒剂进行现场消毒的效果检测 Fig. 5 Assessment of the disinfection effectiveness of three disinfectants in on-site disinfection |

|
| A:光滑表面;B:有孔有缝表面。 图 6 3种消毒剂进行现场消毒的效果评价 Fig. 6 Evaluation of the disinfection effect of three disinfectants in on-site disinfection |
500 mg/L含氯消毒剂对有孔有缝表面的消毒效果与其对光滑表面的类似,在消毒后1 min~5 min的平均杀灭率均大于90%。1%过氧化氢对有孔有缝表面的消毒效果略低于其对光滑表面的消毒效果,在消毒后1 min时的平均杀灭率仅为74.11%,3 min时的平均杀灭率提高至83.09%,4 min后的平均杀灭率高于90%。75%乙醇对有孔有缝表面的消毒效果略好于其对光滑表面的消毒效果,在消毒后1 min时的平均杀灭率为56.71%,4 min后的平均杀灭率高于90%(见图 5B、图 6B)。
3 讨论消毒是切断传染病传播途径的有力手段,对控制传染病流行,保护人群身体健康具有重要意义。新型冠状病毒疫情防控期间,大规模且持久的疫情防控工作暴露出现场消毒技术和评价手段的落后,难以满足现场物品低耗损、人员低风险和快速处置的需求[6]。集中隔离用房和定点救治医院床位紧张时,亟须采用快速消毒技术。随着疫情防控工作对消毒产品需求的剧增,新型产品层出不穷,但同时也存在各种良莠不齐的复杂情况,给实际使用带来了各种隐患。因此,新技术在现场消毒处置中的应用效果须用科学、规范的方式进行评价,且满足现场快速评估的需求。
对于快速消毒剂的选择须关注以下几个方面。①消毒效果:确保选择的消毒剂能够有效杀灭目标微生物。②安全性:消毒剂在使用过程中对人体和环境的安全性很重要。应尽量选择不刺激皮肤和呼吸系统的产品,避免使用有毒物质或对皮肤有害的化学物质。③杀菌速度:快速消毒剂通常须在较短的时间内完成杀菌作用,这对于一些特定环境(如医疗场所、食品加工等)尤为重要。④适用范围:不同的消毒剂可能有不同的适用范围和场景,比如家庭用、医疗设施用、工业用等,选择时要根据具体需要进行考虑。⑤易用性:消毒剂的使用方法和操作简便程度也是须考虑的因素之一,特别是在需要频繁使用时更为重要。
为了研究目前常用的消毒剂在不同场景下的消毒效果,本研究比较了具有代表性的几种快速消毒试剂(75%乙醇、1%过氧化氢、500 mg/L含氯消毒剂)在消毒后1 min~5 min对光滑表面及有孔有缝表面的消毒效果。研究发现,75%乙醇的消毒效果明显低于其他2种消毒剂,且其在消毒后1 min时对现场细菌的平均杀灭率仅为50%左右。
在市面上常见的几种具有杀灭微生物特性的脂肪族醇中,乙基醇(乙醇)、异丙醇(异丙醇,2-丙醇)和正丙醇最常用。其中,乙醇属于中效消毒剂,可以快速杀灭细菌繁殖体、结核杆菌及大多数真菌和病毒。检测乙醇在不同时间范围内对几种病原微生物的杀灭效果发现:铜绿假单胞菌、粘质沙雷氏菌、大肠埃希菌和伤寒沙门氏菌在10 s内可被不同体积比的乙醇(40%~100%)杀灭,其中大肠埃希菌仅需30%体积比的乙醇;金黄色葡萄球菌和化脓性链球菌的耐药性稍强,乙醇体积比为60%~95%时可在10 s内将细菌杀灭[7]。然而,这类基于脂肪族醇的消毒剂对于细菌芽孢、真菌以及亲水病毒的消杀作用有限,尤其是对亲水病毒的杀病毒活性,如甲型肝炎病毒、脊髓灰质炎病毒、手足口病毒等[8-9];且乙醇的消毒浓度须保持在75%左右,高于80%或低于70%时的消毒作用均大幅度降低。其主要原因在于,脂肪醇是通过引起蛋白质变性来发挥其抗菌活性的,水在此类消毒剂的配方中起着重要的作用,只有在含有一定水分的情况下,蛋白质才不会迅速变性。因此70%乙醇溶液是一种比纯乙醇(99%)更有效的消毒剂[10],但当其浓度降至50%以下时,其杀菌效果也会大幅度下降[11]。乙醇作为消毒剂时的浓度可以表示为重量/重量百分比(w/w)和最常见的体积/体积百分比(v/v),这个值可在一定程度上反映消毒剂中的乙醇成分与挥发速率,因此尤为重要。本实验所使用的75%乙醇溶液对大肠埃希菌8099和金黄色葡萄球菌(ATCC 6538)的杀灭效果在消杀时间延长后下降,这主要与其挥发速率有关。且多孔平面的表面积会有一定程度的增大,更加速了乙醇的挥发。因此在脂肪醇类,特别是如乙醇这样的短链醇类,消毒剂的制备和使用过程中,可以考虑加入表面活性剂,或与碱、无机酸、过氧化氢等产品混合使用,以维持其长效消杀效果。
另一种待考察的消毒剂为含氯消毒剂。卤素氯和释放氯的化合物是历史上使用最广泛的抗菌剂。目前常见的含氯消毒剂主要通过释氯作用实现消毒杀菌,可以杀灭各种细菌繁殖体、病毒、真菌以及芽孢。含氯消毒剂的特点是杀菌效率高,使用成本较低,但对人体毒性大,有刺激性和腐蚀性。因此在使用含氯消毒剂时须对其成分、配置和使用机理进行详尽的了解。国内销售的次氯酸钠浓度约为5%~6%,pH值约为11,有一定的刺激性;而当次氯酸钠浓度达到10%~15%时,其pH值约为13,具有燃烧属性和一定的腐蚀性[12]。含氯消毒剂的主要作用机理是次氯酸钠一旦溶于水[见公式(1)~(3)]就会产生2种消杀成分,即次氯酸盐离子(OCl-)及其对应的酸[次氯酸(HOCl)],二者的百分比由水相的pH值决定[13],并进一步影响消杀效果。由于次氯酸不带电荷,故能更好地穿透微生物细胞壁或任何保护层,并通过氧化蛋白质侧链有效地杀死微生物。
| $ \mathrm{OCl}^{-}+\mathrm{H}_2 \mathrm{O} \rightleftharpoons \mathrm{HOCl}+\mathrm{OH}^{-} $ | (1) |
| $ \mathrm{HOCl}+\mathrm{H}^{+}+\mathrm{Cl}^{-} \rightleftharpoons \mathrm{Cl}_2+\mathrm{H}_2 \mathrm{O} $ | (2) |
| $ 2 \mathrm{HOCl}+\mathrm{OCl}^{-} \rightarrow \mathrm{ClO}_3^{-}+2 \mathrm{Cl}^{-}+\mathrm{H}^{+} $ | (3) |
根据AOAC杀结核菌试验,低浓度的游离氯对支原体(25 mg/L)和营养细菌(< 1 mg/L)均具有杀灭作用。杀灭结核分枝杆菌需要更高浓度(1 000 mg/L)的游离氯[14]。本研究发现,含氯消毒剂的消毒效果较好,且起效较快,消毒1 min后对光滑表面及有孔有缝表面上的细菌的平均杀灭率均大于95%,且5 min后的平均杀灭率仍然大于95%。这主要是因为在有孔有缝隙表面,含氯消毒剂可通过缓释其含氯成分实现长效消毒,因此含氯消毒剂更适用于对凹凸不平的物体表面和在具有障碍物的空间开展消杀工作。含氯消毒剂的浓度对杀菌效果会有一定的影响,但这种影响要小于乙醇,故当含氯消毒剂浓度较低时可延长作用时间。含氯消毒剂的特点包括强力杀菌,对于病毒、细菌和真菌有效,适用于硬表面和水处理的消毒。但含氯消毒剂有一定的刺激作用,浓度过高时对人体呼吸道有刺激作用,且对物品有腐蚀作用。
多年来,过氧化氢(H2O2)已被广泛认为对多种微生物(如细菌、病毒、孢子和真菌)具有抗菌特性[15],其所涉及的抗菌机制归因于氧自由基(羟基)的迅速释放。这些自由基是强氧化剂,能迅速与细菌的生物分子(如蛋白质的巯基等)发生反应,从而进一步引起不可逆的结构变化,最终导致病原菌死亡[16]。过氧化氢是一种万能消毒剂,具有无色无味、低生态毒性、适用于多种环境(包括空气、水和物体表面)等特点。通常,实验室使用6%的过氧化氢水溶液进行表面清洁。但过氧化氢溶液对耐药细菌孢子和原生动物包囊的杀菌和杀孢效果较差,这主要是因为过氧化氢溶液不够稳定,导致暴露时间相对较短[17]。因此,在使用过氧化氢溶液作为消毒剂时常使用苯甲酸等合适的稳定剂进行补充。另一方面,由于过氧化氢作为消毒剂使用后的最终产物是氧气和水,对环境和人体无毒无害,这一可生物降解的特性成为其在实际应用中的重大优势,特别是过氧化氢在蒸发形态下可形成更为高效的气溶胶消毒模式,对表面消毒和空旷空间的大面积快速消毒尤为适用。有研究显示,蒸发气溶胶形态的过氧化氢可对存在于医院病房表面的非包膜病毒、分枝杆菌和一些多重耐药微生物实现高效抑制[18],减少多孔和非平整表面的细菌污染情况[19],甚至其气溶胶形态可实现对肠道和呼吸道病原体(包括腺病毒5型、脊髓灰质炎病毒sabin1、轮状病毒SA11)的消杀作用,对结核分枝杆菌和艰难梭菌也具有较好的抑制作用[20]。基于以上信息,本研究发现1%过氧化氢作为高效消毒剂的消毒效果较好,但相较于含氯消毒剂,其起效相对慢,消毒1 min时,其对光滑表面及有孔有缝表面的平均杀灭率分别为79.31%和74.11%。对光滑表面的平均杀灭率在2 min后大于90%,而对有孔有缝表面的平均杀灭率在3 min后大于90%。过氧化氢消毒剂对有孔多缝表面的消杀作用主要是通过形成一定的氧自由基扩散而实现,进一步提高这类试剂的浓度并进行雾化处理将更适用于对空旷大空间进行高效快速消杀。
4 结语本研究发现,在现场消毒效果评价中,75%乙醇作用1 min后对2种表面上细菌的平均杀灭率均仅为50%,作用5 min后其对光滑表面上细菌的平均杀灭率仍低于90%,须适当延长作用时间才能达到消毒效果。而1%过氧化氢作用1 min后,其在2种表面上对细菌的平均杀灭率为70%,5 min后可达90%。含氯消毒剂的现场消毒效果较好,且起效较快,但含氯消毒剂对人体呼吸道有刺激作用,且对物品有腐蚀作用。因此,在选择快速消毒剂时,须综合考虑消毒剂的消毒效果、起效时间及其对环境的有害程度等因素。
| [1] |
Yu SY, Xie ZH, Wu XY, Zheng YZ, Shi Y, Xiong ZK, Zhou P, Liu Y, He CS, Pan ZC, Wang KJ, Lai B. Review of advanced oxidation processes for treating hospital sewage to achieve decontamination and disinfection[J]. Chinese Chemical Letters, 2024, 35(1): 140-152.
[URI]
|
| [2] |
Saint S, Kowalski CP, Kaufman SR, Hofer TP, Kauffman CA, Olmsted RN, Forman J, Banaszak-Holl J, Damschroder L, Krein SL. Preventing hospital-acquired urinary tract infection in the United States: a national study[J]. Clin Infect Dis, 2008, 46(2): 243-250.
[DOI]
|
| [3] |
Amini Tapouk F, Nabizadeh R, Mirzaei N, Hosseini Jazani N, Yousefi M, Valizade Hasanloei MA. Comparative efficacy of hospital disinfectants against nosocomial infection pathogens[J]. Antimicrob Resist Infect Control, 2020, 9(1): 115.
[DOI]
|
| [4] |
Xie M, Gao M, Yun Y, Malmsten M, Rotello VM, Zboril R, Akhavan O, Kraskouski A, Amalraj J, Cai X, Lu J, Zheng H, Li R. Antibacterial nanomaterials: mechanisms, impacts on antimicrobial resistance and design principles[J]. Angew Chem Int Ed Engl, 2023, 62(17): e202217345.
[DOI]
|
| [5] |
国家疾病预防控制局. 中华人民共和国卫生行业标准消毒产品检测方法WS/T 10009—2023[S/OL]. 北京: 国家疾病预防控制局, 2023[2023-12-15]. https://www.ndcpa.gov.cn/jbkzzx/c100203/common/content/content_1813493255079~047168.html.
|
| [6] |
Cozad A, Jones RD. Disinfection and the prevention of infectious disease[J]. Am J Infect Control, 2003, 31(4): 243-254.
[DOI]
|
| [7] |
Centers for Disease Control and Prevention. Guideline for disinfection and sterilization in healthcare facilities, 2008[S/OL]. Atlanta: centers for disease control and prevention, 2023[2024-06-01]. https://www.cdc.gov/infection-control/media/pdfs/Guideline-Disinfection-H.pdf.
|
| [8] |
Doerrbecker J, Friesland M, Ciesek S, Erichsen TJ, Mateu-Gelabert P, Steinmann J, Steinmann J, Pietschmann T, Steinmann E. Inactivation and survival of hepatitis C virus on inanimate surfaces[J]. J Infect Dis, 2011, 204(12): 1830-1838.
[DOI]
|
| [9] |
Underwood MA, Pirwitz S. APIC guidelines committee: using science to guide practice. Association for professionals in infection control and epidemiology[J]. Am J Infect Control, 1999, 27(2): 141-144.
[DOI]
|
| [10] |
Gilbert P, McBain AJ. Potential impact of increased use of biocides in consumer products on prevalence of antibiotic resistance[J]. Clin Microbiol Rev, 2003, 16(2): 189-208.
[DOI]
|
| [11] |
Salvage R, Hull CM, Kelly DE, Kelly SL. Use of 70% alcohol for the routine removal of microbial hard surface bioburden in life science cleanrooms[J]. Future Microbiol, 2014, 9(10): 1123-1130.
[DOI]
|
| [12] |
World Health Organization. Laboratory biosafety manualn[M/OL]. 3rd ed. Geneva: World Health Organization, 2004. https://iris.who.int/bitstream/handle/10665/42981/9241546506_eng.pdf?sequence=1.
|
| [13] |
Winter J, Ilbert M, Graf PC, Ozcelik D, Jakob U. Bleach activates a redox-regulated chaperone by oxidative protein unfolding[J]. Cell, 2008, 135(4): 691-701.
[DOI]
|
| [14] |
Rutala WA, Cole EC, Wannamaker NS, Weber DJ. Inactivation of Mycobacterium tuberculosis and Mycobacterium bovis by 14 hospital disinfectants[J]. Am J Med, 1991, 91(3B): 267S-271S.
[DOI]
|
| [15] |
Davoudi M, Ehrampoush MH, Vakili T, Absalan A, Ebrahimi A. Antibacterial effects of hydrogen peroxide and silver composition on selected pathogenic enterobacteriaceae[J]. Int J Env Health Eng, 2012, 1(2): 23.
[DOI]
|
| [16] |
Steinberg D, Heling I, Daniel I, Ginsburg I. Antibacterial synergistic effect of chlorhexidine and hydrogen peroxide against Streptococcus sobrinus, Streptococcus faecalis and Staphylococcus aureus[J]. J Oral Rehabil, 1999, 26(2): 151-156.
[DOI]
|
| [17] |
McDonnell G. The use of hydrogen peroxide for disinfection and sterilization applications[M]//In PATAI'S Chemistry of Functional Groups. Peroxides(2014). New York: John Wiley & Sons, Ltd, 2014: 1-34. https://onlinelibrary.wiley.com/doi/epdf/10.1002/9780470682531.pat0885.
|
| [18] |
Totaro M, Casini B, Profeti S, Tuvo B, Privitera G, Baggiani A. Role of hydrogen peroxide vapor (HPV) for the disinfection of hospital surfaces contaminated by multiresistant bacteria[J]. Pathogens, 2020, 9(5): 408.
[DOI]
|
| [19] |
Weber DJ, Kanamori H, Rutala WA. 'No touch' technologies for environmental decontamination: focus on ultraviolet devices and hydrogen peroxide systems[J]. Curr Opin Infect Dis, 2016, 29(4): 424-431.
[DOI]
|
| [20] |
Tuladhar E, Terpstra P, Koopmans M, Duizer E. Virucidal efficacy of hydrogen peroxide vapour disinfection[J]. J Hosp Infect, 2012, 80(2): 110-115.
[DOI]
|
 2024, Vol. 19
2024, Vol. 19


